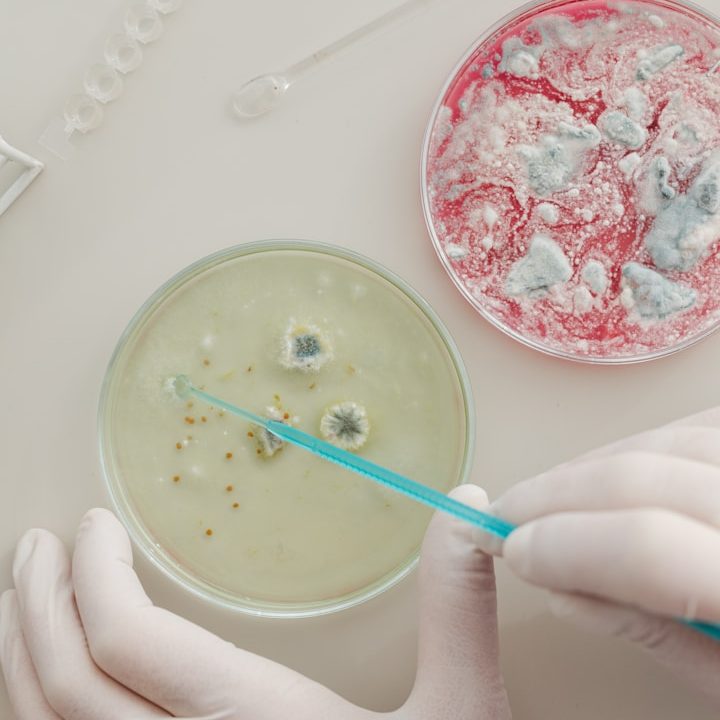
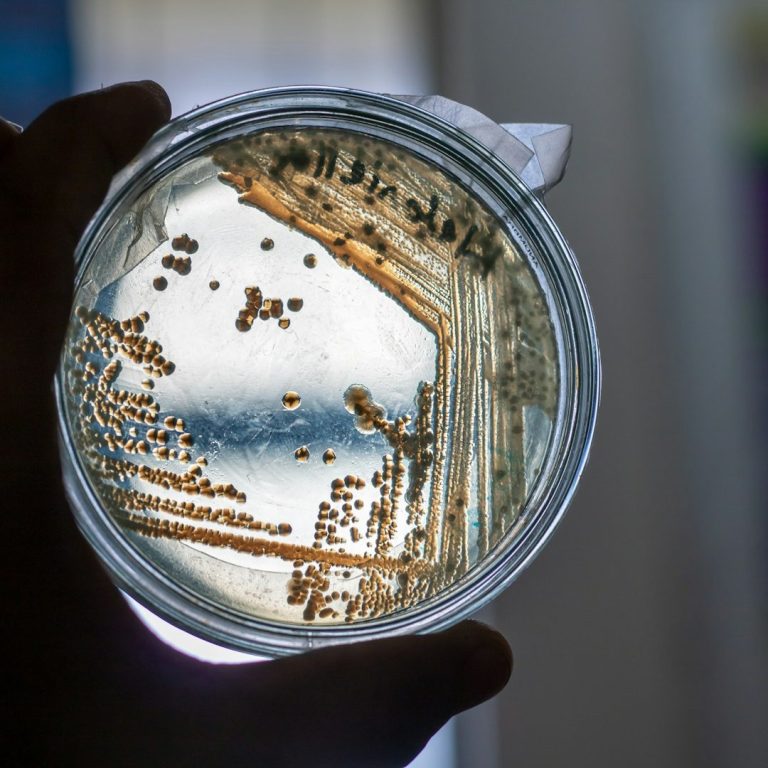

ANTIMICROBIAL RESISTANCE:
WHAT EVERY FAMILY SHOULD KNOW
Antimicrobial resistance is on the rise globally. What does this mean for you? for your families? and for everyone else?

What is Antimicrobial Resistance?
Antimicrobial resistance (AMR) is where microscopic germs such as bacteria stop responding to antibiotics designed to kill them.
This leads to infections becoming harder to treat, spreading more rapidly, and becoming more dangerous to the already vulnerable populations such as children and the elderly.
The more we continue to misuse antibiotics, the faster resistance grows. Working together now is key to minimizing the growth and spread of AMR, and educating the public on how they can help is the first key step in doing so.
What You Should Know
Why should parents especially be concerned? What responsibilities do we hold? How does it affect our families?
What can you do to protect your family and loved ones from AMR? And what are the best steps forward?
Find out how our ongoing research and new discoveries are helping us fight against antimicrobial resistance.
36.5%
Hospital Infections
5 Million
AMR Contributed Deaths In 2019
1 Million
Projected AMR Deaths Anually by 2050




